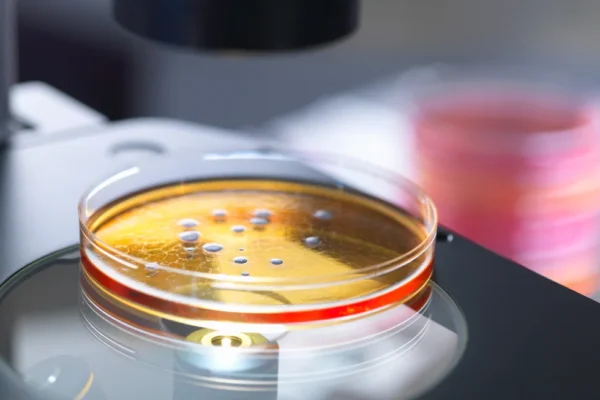

White Lotus’ Season 3 Reveals Its Reservation Date
A Return to Opulence and Intrigue Fans of The White Lotus can rejoice as HBO announces the premiere date for its highly anticipated third season: March 17, 2025. Set in a lavish resort in the Maldives, this season promises a fresh blend of dark comedy and mystery. New Faces, New Stories The star-studded cast includes…